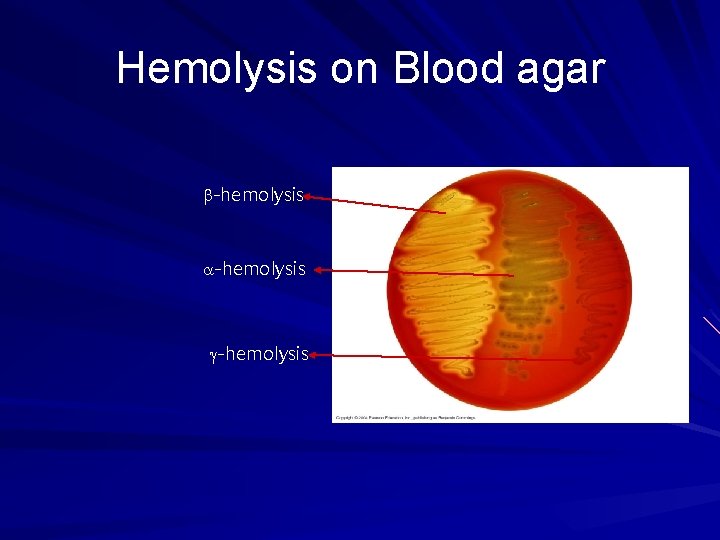
Hemolysis on Blood agar -hemolysis Hemolysis on Blood agar -hemolysis

Streptococci Characters of Streptococci Gram positive cocci 1m

- Slides: 34
Streptococci Characters of Streptococci – – – Gram positive cocci 1µm in diameter Chains or pairs Usually capsulated Non motile – – Non spore forming Facultative anaerobes Fastidious Catalase negative (Staphylococci are catalase positive)
Classification of Streptococci can be classified according to: – Oxygen requirements Anaerobic (Peptostreptococcus) Aerobic or facultative anaerobic (Streptococcus) – Serology (Lanciefield Classification) – Hemolysis on Blood Agar (BA)
Serology: Lanciefield Classification Streptococci Lanciefield classification Group A S. pyogenes Group B S. agalactiae Group C S. equisimitis Group D Enterococcus Other groups (E-U) Streptococci classified into many groups from A-K & H-V One or more species per group Classification based on C- carbohydrate antigen of cell wall – Groupable streptococci A, B and D (more frequent) C, G and F (Less frequent) – Non-groupable streptococci S. pneumoniae (pneumonia) viridans streptococci – e. g. S. mutans – Causing dental carries
Classification of Streptococci Based on Hemolysis on Blood Agar Hemolysis on BA – -hemolysis Partial hemolysis Green discoloration around the colonies e. g. non-groupable streptococci (S. pneumoniae & S. viridans) – -hemolysis Complete hemolysis Clear zone of hemolysis around the colonies e. g. Group A & B (S. pyogenes & S. agalactiae) – -hemolysis Streptococci No lysis e. g. Group D (Enterococcus spp) -hemolysis
Rebecca Lancefield Classifies Streptococcus Dr. T. V. Rao MD 6
Hemolysis on Blood agar -hemolysis
Group A streptococci Include only S. pyogenes Group A streptococcal infections affect all ages peak incidence at 5 -15 years of age 90% of cases of pharyngitis
Classification Based on O 2 requirement Aerobes Anaerobe s Peptostreptococ ci γ hemolysis Growth on BA α β hemolysis Incomplete Complete hemolysis (green color)Lancefield grouping Strep. viridans Strep. pneumoniae α / β / no hemolysis Enterococcus fecalis specific C carbohydrate Ag on cell wall Group A – U (21 groups) Griffith typing of Group A on MTR proteins into > 100 9 Dr. T. V. Rao MD types
Transmission Initially colonizes skin and pharynx Person-to-person spread Strains that cause skin – infections are spread via skin contact Strains that cause respiratory – infections are spread via respiratory droplets Less common is food or waterborne The immunucompromised are especially susceptible http: //www. cellsalive. net/phot
Pathogenesis and Virulence Factors Structural components – M protein M, which interferes with opsonization and lysis of the bacteria – Lipoteichoic acid & F protein adhesion – Hyaluronic acid capsule, which acts to camouflage the bacteria Enzymes – Streptokinases – Deoxynucleases facilitate the spread of streptococci through tissues – C 5 a peptidase Pyrogenic toxins that stimulate macrophages and helper T cells to release cytokines Streptolysins – Streptolysin O lyse red blood cells, white blood cells, and platelets – Streptolysin S
Virulence Factors Cont’d ◄ ► ► Image taken from: http: //www. textbookofbacteriology. net/streptococcus. Mitchell
Streptococcal pyrogenic exotoxins (Spe) Produced by both the scarlet fever strains and new invasive S. pyogenes strains. More than four serologically distinct toxins (Spe. A, B, C and F). They are superantigens (except for Spe. B, which is a cysteine protease) and may exhibit the following biological activities: Enhances release of proinflammatory cytokines (pyrogenicity) causes skin rash Immunosuppression Spe is associated with streptococcal toxic shock syndrome or other invasive S. pyogenes diseases.
Disease caused by S. pyogenes Suppurative – Non-Invasive Pharyngitis (“strep throat”)-inflammation of the pharynx Skin infection, Impetigo – Invasive Scarlet fever-rash that begins on the chest and spreads across the body Pyoderma-confined, pus-producing lesion that usually occurs on the face, arms, or legs Necrotizing fasciitis-toxin production destroys tissues and eventually muscle and fat tissue Non Suppurative – Rheumatic fever: Life threatening inflammatory disease that leads to damage of heart valves muscle – Glomerulonephritits Immune complex disease of kidney inflammation of the glomeruli and nephrons which obstruct blood flow through the kidneys
Strep Throat S. pyogenes is leading cause of uncomplicated bacterial pharyngitis and tonsillitis Common in winter and early spring in children over age 3 Typical symptoms: Pus in throat Reddened and inflamed tonsils and uvula Tiny, reddish-brown spots at back of throat Swollen lymph nodes and tongue – – Treatment is best 48 hours after symptom onset http: //www. lib. uiowa. edu/hardin/md/strepthroa
Erysipelas Acute infection and imflammation of the dermal layer of skin. Painful red patches which enlarge and thicken Treatment -penicillin or erythromycin
Erysipelas
Scarlet fever If the strain of S. pyogenes is lysogenic for a particular phage which expresses an erythrogenic toxin the result is Scarlet fever Rash appears and characteristic is the strawberry colored tongue
Strawberry Tongue
S. pyogenes Necrotizing Fasciitis “Flesh-eating bacteria” 600 cases annually in US Rapidly progressive http: //www. aic. cuhk. edu. hk/web 8/toc. htm Any part of body can be infected Common in abdomen, perineum, and extremities – Patients present with red skin, lesions Untreated patients will die within 4 days http: //catalog. nucleusinc. com/ge nerateexhibit. php? ID=11447&Exhi bit. Keywords. Raw=&TL=16353&A
Necrotising Fascitis
Post streptococcal diseases Rheumatic Feverautoimmune disease involving heart valves, joints, nervous system. Follows a strep throat Acute glomerulonephritis or Bright’s Diseaseinflammatory disease of renal glomeruli and structures involved in blood filter of kidney. Due to deposition of Ag/Ab complexes. Dr. T. V. Rao MD 22
Differentiation between -hemolytic streptococci The following tests can be used to differentiate between -hemolytic streptococci – Lanciefield Classification – Bacitracin susceptibility Test Specific for S. pyogenes (Group A) – CAMP test Specific for S. agalactiae (Group B)
Bacitracin sensitivity Principle: – Bacitracin test is used for presumptive identification of group A – To distinguish between S. pyogenes (susceptible to B) & non group A such as S. agalactiae (Resistant to B) – Bacitracin will inhibit the growth of gp A Strep. pyogenes giving zone of inhibition around the disk Procedure: – Inoculate BAP with heavy suspension of tested organism – Bacitracin disk (0. 04 U) is applied to inoculated BAP – After incubation, any zone of inhibition around the disk is considered as susceptible
CAMP test Principle: – Group B streptococci produce extracellular protein (CAMP factor) – CAMP act synergistically with staph. -lysin to cause lysis of RBCs Procedure: – Single streak of Streptococcus to be tested and a Staph. aureus are made perpendicular to each other – 3 -5 mm distance was left between two streaks – After incubation, a positive result appear as an arrowhead shaped zone of complete hemolysis – S. agalactiae is CAMP test positive while non gp B streptococci are negative
CAMP test
Differentiation between -hemolytic streptococci The following definitive tests used to differentiate between S. pneumoniae & viridans streptococci – Optochin Test – Bile Solubility Test – Inulin Fermentation
Optochin Susceptibility Test Principle: – Optochin (OP) test is presumptive test that is used to identify S. pneumoniae – S. pneumoniae is inhibited by Optochin reagent (<5 µg/ml) giving a inhibition zone ≥ 14 mm in diameter. Procedure: – – – BAP inoculated with organism to be tested OP disk is placed on the center of inoculated BAP After incubation at 37 o. C for 18 hrs, accurately measure the diameter of the inhibition zone by the ruler – ≥ 14 mm zone of inhibition around the disk is considered as positive and ≤ 13 mm is considered negative S. pneumoniae is positive (S) while S. viridans is negative (R)
Optochin Susceptibility Test Optochin resistant S. viridans Optochin susceptible S. pneumoniae
Bile Solubility test Principle: – S. pneumoniae produce a self-lysing enzyme to inhibit the growth – The presence of bile salt accelerate this process Procedure: – Add ten parts (10 ml) of the broth culture of the organism to be tested to one part (1 ml) of 2% Na deoxycholate (bile) into the test tube – Negative control is made by adding saline instead of bile to the culture – Incubate at 37 o. C for 15 min – Record the result after 15 min
Bile Solubility test Results: – Positive test appears as clearing in the presence of bile while negative test appears as turbid – S. pneumoniae soluble in bile whereas S. viridans insoluble
Differentiation between -hemolytic streptococci Hemolysis Bacitracin sensitivity CAMP test S. pyogenes Susceptible Negative S. agalactiae Resistant Positive Differentiation between -hemolytic streptococci Hemolysi Optochin Bile Inulin s sensitivit solubilit Fermentation y y S. pneumoniae Sensitive (≥ 14 mm) Soluble Not ferment Viridans strep Resistant (≤ 13 mm) Insoluble Ferment
Potential Vaccines Recombinant Serotypic – determinant approach Streptavax. TM Conserved region – approach Synthetic peptide http: //www. auburnschl. edu/Other. Info/immunizations.
Conclusions Causes numerous diseases Increasing bacterial resistance to treatment Many virulence factors provide options for vaccine development Currently, the M protein is – our best vaccine target option, and Streptavax. TM is our best hope for a vaccine http: //www. microbiology. emory. edu/scott/index_main.